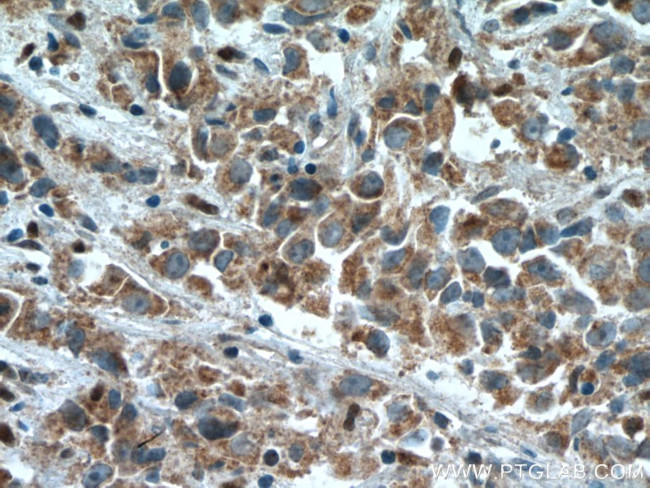
STEAP4 Antibody in Immunohistochemistry (Paraffin) (IHC (P))

Search
Proteintech
STEAP4 Polyclonal Antibody
{{$productOrderCtrl.translations['antibody.pdp.commerceCard.promotion.promotions']}}
{{$productOrderCtrl.translations['antibody.pdp.commerceCard.promotion.viewpromo']}}
{{$productOrderCtrl.translations['antibody.pdp.commerceCard.promotion.promocode']}}: {{promo.promoCode}} {{promo.promoTitle}} {{promo.promoDescription}}. {{$productOrderCtrl.translations['antibody.pdp.commerceCard.promotion.learnmore']}}
产品信息
11944-1-AP
种属反应
已发表种属
宿主/亚型
分类
类型
抗原
偶联物
形式
浓度
规格
纯化类型
保存液
内含物
保存条件
运输条件
产品详细信息
Immunogen sequence: MEKTCIDAL PLTMNSSEKQ ETVCIFGTGD FGRSLGLKML QCGYSVVFGS RNPQKTTLLP SGAEVLSYSE AAKKSGIIII AIHREHYDFL TELTEVLNGK ILVDISNNLK INQYPESNAE YLAHLVPGAH VVKAFNTISA WALQSGALDA SRQAILKKEN PFSTSSAWLS DSYVALGILG FFLFVLLGIT SLPSVSNAVN WREFRFVQSK LGYLTLILCT AHTLVYGGKR FLSPSNLRWY LPAAYVLGLI IPCTVLVIKF VLIMPCVDNT LTRIRQGWER NSKH (1-283 aa encoded by BC020600)
靶标信息
The six-transmembrane epithelial antigen of prostate 4 (STEAP4) is a member of a family of metalloreductases identified as cell-surface antigens in prostate tissue. Similar to two other members of the STEAP family (STEAP 2 and STEAP3), STEAP4 promotes both iron and copper reduction. STEAP4 is highly expressed in placenta, lung, heart and prostate tissues, and overexpressed in prostate cancer cells compared to normal prostate cells. Overexpression of STEAP4 in prostate cells significantly increases cell growth and colony formation, suggesting STEAP4 may have a role in cell proliferation and prostate cancer progression.
仅用于科研。不用于诊断过程。未经明确授权不得转售。
生物信息学
蛋白别名: Ab1-219; DKFZp666D049; dudulin 4; Dudulin-4; FLJ23153; Metalloreductase STEAP4; seven chromosome locus associated with HCC; six transmembrane prostate protein 2; Six-transmembrane epithelial antigen of prostate 4; SixTransMembrane protein of prostate 2; STEAP family member 4; STMP2v1; STMP2v2; Tnfa-induced adipose-related protein; Tumor necrosis factor, alpha-induced protein 9; Tumor necrosis factor-alpha-induced adipose-related protein; tumor necrosis-alpha-induced adipose-related protein; unnamed protein product
基因别名: 1110021O17Rik; AI481214; SchLAH; STAMP2; STEAP4; TIARP; TNFAIP9
UniProt ID: (Human) Q687X5, (Rat) Q4V8K1, (Mouse) Q923B6
Entrez Gene ID: (Human) 79689, (Rat) 499991, (Mouse) 117167